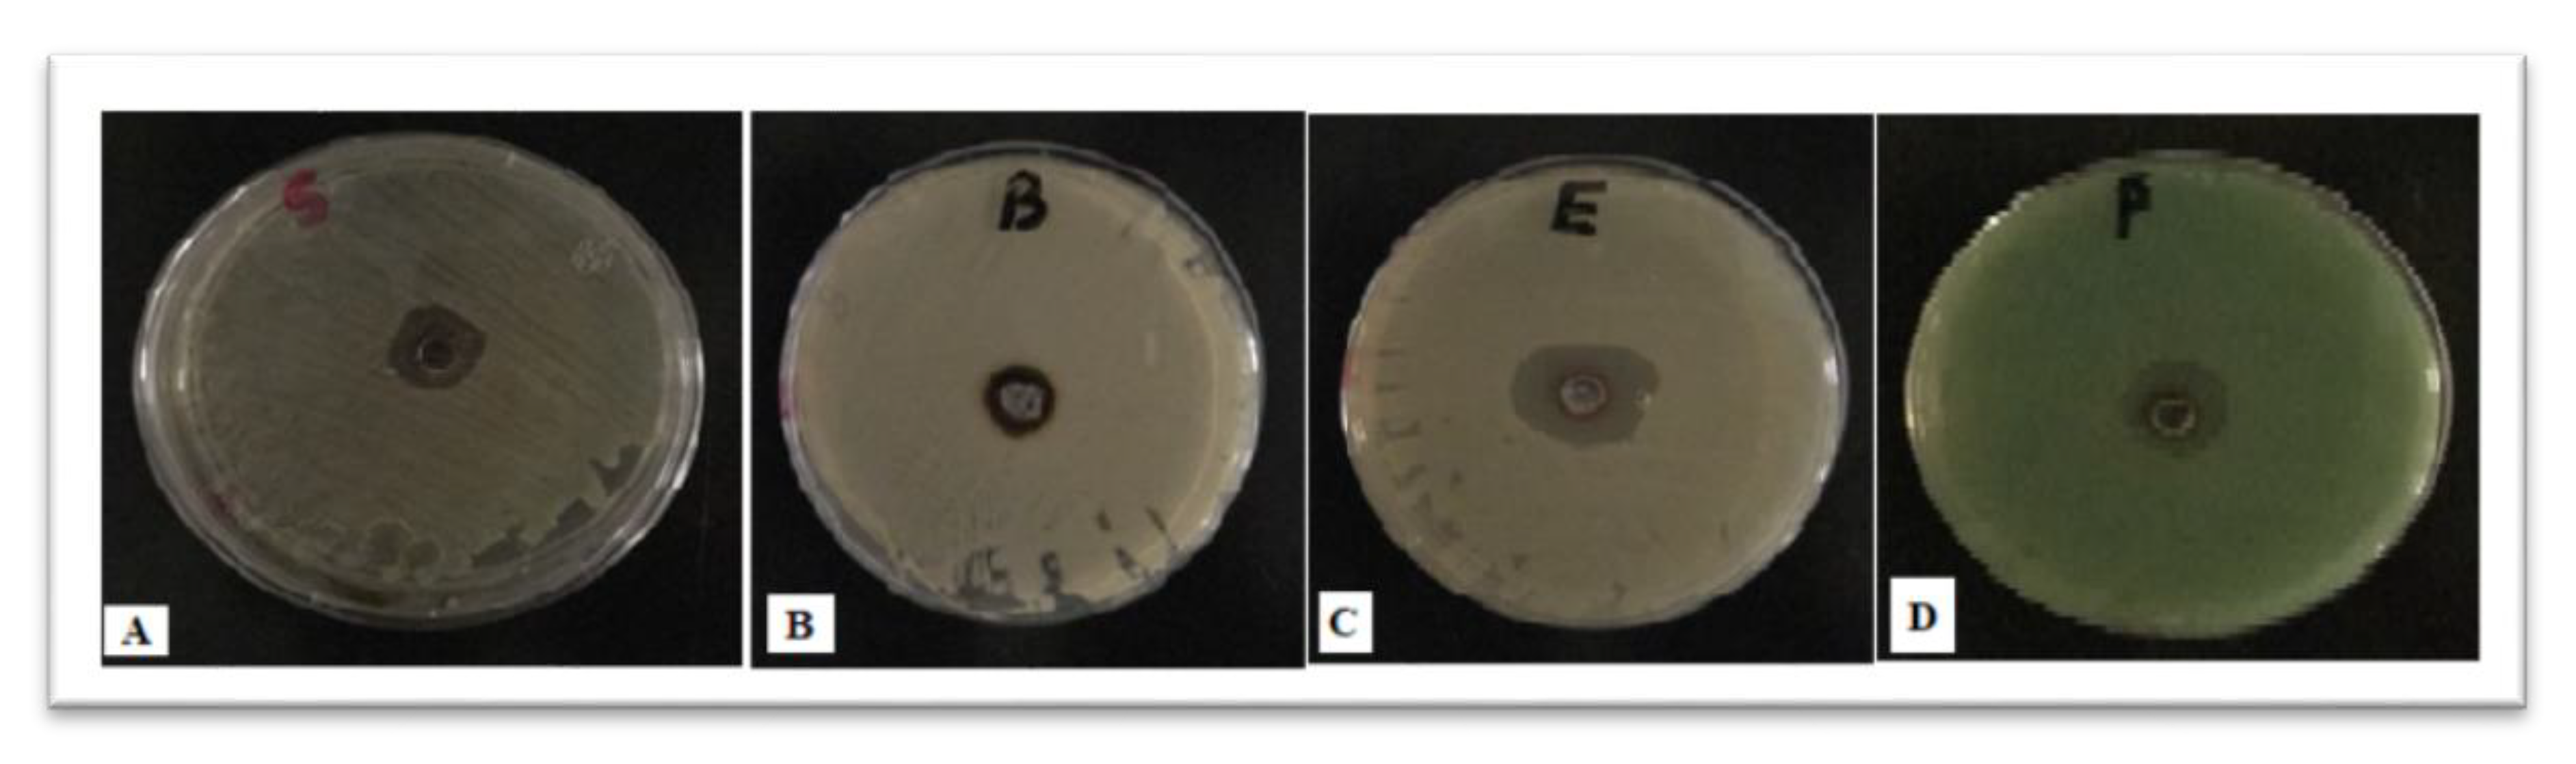
Materials 12 03890 g006

Novel Eco-Synthesis of PD Silver Nanoparticles: Characterization, Assessment of Its Antimicrobial and Cytotoxicity Properties
Abstract
1. Introduction
2. Methodology and Materials
2.1. Preparation of Bio AgNPs
2.2. Characterization of Bio NPs
2.3. Assessment of Microbial Activity
2.4. Evaluation of Cytotoxic Effects
3. Results and Discussion
3.1. Visual Examination and UV-Vis Spectral Analysis of Bio AgNPs
3.2. Particle Size Determination by DLS
3.3. TEM Analysis of PD AgNPs
3.4. EDX Analysis of PD AgNPs
3.5. Evaluation of Antimicrobial Activity of PD AgNPs
3.6. Cytotoxicity Assessments of PD AgNPs
4. Conclusions
Author Contributions
Acknowledgments
Conflicts of Interest
References
- Bhatte, K.D.; Tambade, P.J.; Dhake, K.P.; Bhanage, B.M. Silver nanoparticles as an efficient, heterogeneous and recyclable catalyst for synthesis of β-enaminones. Catal. Commun. 2010, 11, 1233–1237. [Google Scholar] [CrossRef]
- Narayanan, K.B.; Sakthivel, N. Biological synthesis of metal nanoparticles by microbes. Adv. Colloid Interface Sci. 2010, 15, 1–13. [Google Scholar] [CrossRef]
- Carotenuto, G.; Pepe, G.P.; Nicolais, L. Preparation and characterization of nano-sized Ag/PVP composites for optical applications. Eur. Phy. J. B 2000, 16, 11–17. [Google Scholar] [CrossRef]
- Stathatos, E.; Lianos, P.; Falaras, P.; Siokou, A. Photocatalytically deposited silver nanoparticles on mesoporous TiO2 films. Langmuir 2000, 16, 2398–2400. [Google Scholar] [CrossRef]
- Kyriacou, S.V.; Brownlow, W.J.; Xu, X.H.N. Using nanoparticle optics assay for direct observation of the function of antimicrobial agents in single live bacterial cells. Biochemistry 2004, 43, 140–147. [Google Scholar] [CrossRef] [PubMed]
- Feng, X.; Ma, H.; Huang, S.; Pan, W.; Zhang, X.; Tian, F.; Luo, J. Aqueous-organic phase-transfer of highly stable gold, silver, and platinum nanoparticles and a new route for the fabrication of gold nanofilms at the Oil/Water interface and on solid supports. J. Phys. Chem. B 2006, 110, 12311–12317. [Google Scholar] [CrossRef]
- Choi, S.; Kim, K.S.; Yeon, S.H.; Cha, J.H.; Lee, H.; Kim, C.J.; Yoo, I.D. Fabrication of silver nanoparticles via self-regulated reduction by 1-(2-hydroxyethyl)-3-methylimidazolium tetrafluoroborate. Korean J. Chem. Eng. 2007, 24, 856–859. [Google Scholar] [CrossRef]
- Vazquez-Muñoz, R.; Borrego, B.; Juárez-Moreno, K.; García-García, M.; Morales, J.D.M.; Bogdanchikova, N.; Huerta-Saquero, A. Toxicity of silver nanoparticles in biological systems: Does the complexity of biological systems matter? Toxicol. Lett. 2017, 5, 11–20. [Google Scholar] [CrossRef]
- Dakal, T.C.; Kumar, A.; Majumdar, R.S.; Yadav, V. Mechanistic basis of antimicrobial actions of silver nanoparticles. Front. Microbiol. 2016, 7, 1831. [Google Scholar] [CrossRef]
- Ahmed, K.B.R.; Nagy, A.M.; Brown, R.P.; Zhang, Q.; Malghan, S.G.; Goering, P.L. Silver nanoparticles: Significance of physicochemical properties and assay interference on the interpretation of in vitro cytotoxicity studies. Toxicol. Vitr. 2017, 38, 179–192. [Google Scholar] [CrossRef]
- Rajeshkumar, S.; Bharath, L.V. Mechanism of plant-mediated synthesis of silver nanoparticles—A review on biomolecules involved. characterisation and antibacterial activity. Chem. Biol. Interact. 2017, 273, 219–227. [Google Scholar] [CrossRef] [PubMed]
- Von Staden, H. Herophilus: The Art of Medicine in Early Alexandria: Edition, Translation, and Essays; Cambridge University Press: Cambridge, UK, 1989. [Google Scholar]
- Susan, P.M. Galen and the Rhetoric of Healing; The Johns Hopkins University Press: Baltimore, MD, USA, 2008. [Google Scholar]
- Panagiotis, K.; Paul, G. Phosphatic Features. In Interpretation of Micromorphological Features of Soils and Regoliths; Elsevier: Amsterdam, The Netherlands, 2010; ISBN 978-0-444-53156-8. [Google Scholar] [CrossRef]
- Dirk, H.R.S.; Maggie, J.W. Dietary habits of urban pigeons (Columba livia) and implications of excreta Ph—A review. EJE 2017, 3, 27–41. [Google Scholar] [CrossRef]
- Perez, C.; Paul, M.; Bazerque, P. Antibiotic assay by agarwell diffusion method. Acta. Biol. Med. Exp. 1990, 15, 113–115. [Google Scholar]
- Mosmann, T. Rapid colorimetric assay for cellular growth and survival: Application to proliferation and cytotoxicity assays. J. Immunol. Methods 1983, 65, 55–63. [Google Scholar] [CrossRef]
- Gomha, S.M.; Riyadh, S.M.; Mahmmoud, E.A.; Elaasser, M.M. Synthesis and anticancer activities of thiazoles, 1,3-thiazines, and thiazolidine using chitosan-grafted-poly(vinylpyridine) as basic catalyst. Heterocycles 2015, 91, 1227–1243. [Google Scholar] [CrossRef]
- Zhao, J.; Pinchuk, A.O.; McMahon, J.M.; Li, S.; Ausman, L.K.; Atkinson, A.L.; Schatz, G.C. Methods of describing the electromagnetic properties of silver and gold nanoparticles. Chem. Soc. Rev. 2008, 41, 1710–1720. [Google Scholar] [CrossRef]
- Zhang, X.F.; Liu, Z.G.; Shen, W.; Gurunathan, S. Silver nanoparticles: Synthesis, characterization, properties, applications, and therapeutic approaches. Int. J. Mol. Sci. 2016, 17, 1534. [Google Scholar] [CrossRef]
- de Aragao, A.P.; de Oliveira, T.M.; Quelemes, P.V.; Perfeito, M.L.G.; Araujo, M.C.; Santiago, J.D.A.S.; da Silva, D.A. Green synthesis of silver nanoparticles using the seaweed Gracilaria birdiae and their antibacterial activity. Arab. J. Chem. 2016. [Google Scholar] [CrossRef]
- Aidev, L.R.; Narasimha, G. Fungal mediated biosynthesis of silver nanoparticles, characterization and antimicrobial activity. Colloids Surf. B 2010, 81, 430–433. [Google Scholar] [CrossRef]
- Pal, S.; Tak, Y.K.; Song, J.M. Does the antibacterial activity of silver nanoparticles depend on the shape of the nanoparticle? A study of the Gram-negative bacterium Escherichia coli. Appl. Environ. Microbiol. 2007, 73, 1712–1720. [Google Scholar] [CrossRef]
- Mallikarjunaa, K.; John Sushmab, N.; Narasimhac, G. Phytochemical fabrication and characterization of silver nanoparticles by using pepper leaf broth. Arab. J. Chem. 2014, 7, 1099–1103. [Google Scholar] [CrossRef]
- Mallikarjuna, K.; Narasimha, G.; Dillip, G.R.; Praveen, B.; Shreedhar, B.; Lakshmi, C.S.; Raju, B.D.P. Green synthesis of silver nanoparticles using ocimum leaf extract and their characterization. Dig. J. Nanomater. Biostruct. 2011, 6, 181–186. [Google Scholar]
- Magudapathy, P.; Gangopadhyay, P.; Panigrahi, B.K.; Nair, K.G.M.; Dhara, S. Electrical transport studies of Ag nanoparticles embedded in glass matrix. Phys. B Condens. Matter 2001, 299, 142. [Google Scholar] [CrossRef]
- Mahesh, M.C.; Shivayogeeshwar, E.N. Effect of sheep and goat fecal mediated synthesis and characterization of silver nanoparticles (AgNPs) and their antibacterial effects. J. Nanofluids 2018, 7, 309–315. [Google Scholar] [CrossRef]
- Morones, J.R.; Elechiguerra, J.L.; Camacho, A.; Holt, K.; Kouri, J.B.; Ramírez, J.T.; Yacaman, M.J. The bactericidal effect of silver nanoparticles. Nanotechnology 2005, 16, 2346. [Google Scholar] [CrossRef] [PubMed]
- Qing, Y.; Cheng, L.; Li, R.; Liu, G.; Zhang, Y.; Tang, X.; Wang, J.; Liu, H.; Qin, Y. Potential antibacterial mechanism of silver nanoparticles and the optimization of orthopedic implants by advanced modification technologies. Int. J. Nanomed. 2018, 13, 3311–3327. [Google Scholar] [CrossRef]
- Ramesh, P.S.; Kokila, T.; Geetha, D. Plant mediated green synthesis and antibacterial activity of silver nanoparticles using Emblica officinalis fruit extract. Spectrochim. Acta Part A Mol. Biomol. Spectrosc. 2015, 142, 339–343. [Google Scholar] [CrossRef]
- Nair, L.S.; Laurencin, C.T. Silver nanoparticles: Synthesis and therapeutic applications. Biomed. Nanotechnol. 2007, 3, 301–316. [Google Scholar] [CrossRef]
- Abdal Dayem, A.; Hossain, M.K.; Lee, S.B.; Kim, K.; Saha, S.K.; Yang, G.M.; Choi, H.Y.; Cho, S.G. The role of reactive oxygen species (ros) in the biological activities of metallic nanoparticles. Int. J. Mol. Sci. 2017, 18, 120. [Google Scholar] [CrossRef]
- Venugopal, K.; Rather, H.A.; Rajagopal, K.; Shanthi, M.P.; Sheriff, K.; Illiyas, M.; Bhaskar, M.; Maaza, M. Synthesis of silver nanoparticles (Ag NPs) for anticancer activities (MCF 7 breast and A549 lung cell lines) of the crude extract of Syzygium aromaticum. J. Photochem. Photobiol. B Biol. 2017, 167, 282–289. [Google Scholar] [CrossRef]
- Adolfo, V.O.; Alejandro, A.R. Green silver nanoparticles: Novel therapeutic potential for cancer and microbial infections. J. Nanomed. Res. 2017, 6, 162. [Google Scholar] [CrossRef]

© 2019 by the authors. Licensee MDPI, Basel, Switzerland. This article is an open access article distributed under the terms and conditions of the Creative Commons Attribution (CC BY) license (http://creativecommons.org/licenses/by/4.0/).
Share and Cite
A. Awad, M.; M. Alkhulaifi, M.; S. Aldosari, N.; Alzahly, S.; Aldalbahi, A. Novel Eco-Synthesis of PD Silver Nanoparticles: Characterization, Assessment of Its Antimicrobial and Cytotoxicity Properties. Materials 2019, 12, 3890. https://doi.org/10.3390/ma12233890
A. Awad M, M. Alkhulaifi M, S. Aldosari N, Alzahly S, Aldalbahi A. Novel Eco-Synthesis of PD Silver Nanoparticles: Characterization, Assessment of Its Antimicrobial and Cytotoxicity Properties. Materials. 2019; 12(23):3890. https://doi.org/10.3390/ma12233890
Chicago/Turabian StyleA. Awad, Manal, Manal M. Alkhulaifi, Noura S. Aldosari, Shaykha Alzahly, and Ali Aldalbahi. 2019. "Novel Eco-Synthesis of PD Silver Nanoparticles: Characterization, Assessment of Its Antimicrobial and Cytotoxicity Properties" Materials 12, no. 23: 3890. https://doi.org/10.3390/ma12233890
APA StyleA. Awad, M., M. Alkhulaifi, M., S. Aldosari, N., Alzahly, S., & Aldalbahi, A. (2019). Novel Eco-Synthesis of PD Silver Nanoparticles: Characterization, Assessment of Its Antimicrobial and Cytotoxicity Properties. Materials, 12(23), 3890. https://doi.org/10.3390/ma12233890

